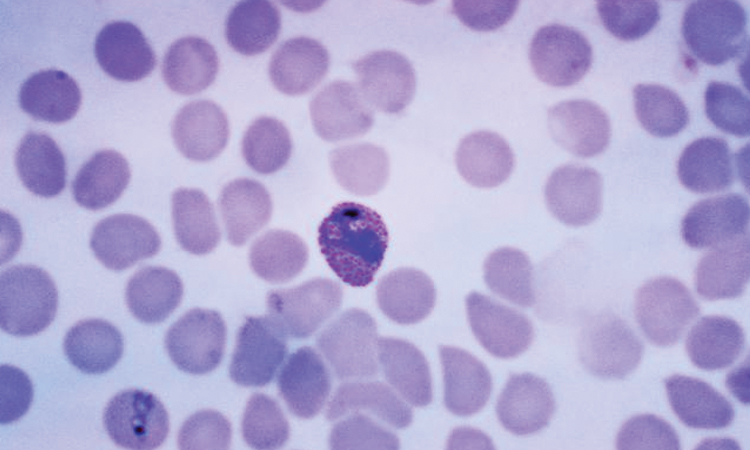

മലേറിയയെ പ്രതിരോധിക്കാം
text_fieldsലോകാരോഗ്യ സംഘടന അടുത്തകാലത്ത് പുറത്തുവിട്ട വേള്ഡ് മലേറിയ റിപ്പോര്ട്ട് -2016ലെ കണക്കനുസരിച്ച് കഴിഞ്ഞ ഒരു വര്ഷത്തിനിടെ, ലോകത്താകമാനം 21 കോടി 20 ലക്ഷത്തിലധികം ആളുകളെ മലമ്പനി അഥവാ മലേറിയ എന്ന രോഗം ബാധിച്ചിട്ടുണ്ട്. അതില് 90 ശതമാനവും ആഫ്രിക്കന് രാജ്യങ്ങളിലാണ്. രോഗബാധിതരില് 4,29,000 പേര് മരിച്ചു. ഇതില് 80 ശതമാനവും അഞ്ച് വയസ്സിനു താഴെയുള്ള കുട്ടികളാണെന്നതാണ് ഞെട്ടിക്കുന്ന യാഥാര്ഥ്യം. ഭൂമിയില് ഓരോ രണ്ടു മിനിറ്റിലും ഓരോ കുട്ടികള് മലേറിയ ബാധിച്ച് മരിക്കുന്നുണ്ടെന്നാണ് കണക്ക്. രോഗവാഹകനെ കണ്ടെത്തിയത് ഇന്ത്യയിലാണ്. മറ്റു രാഷ്ട്രങ്ങള്ക്ക് കഴിഞ്ഞ ഏതാനും വര്ഷങ്ങളായി മലേറിയ ബാധയെ നിയന്ത്രിക്കാന് കഴിഞ്ഞിട്ടുണ്ടെങ്കിലും ആഫ്രിക്കന് രാജ്യങ്ങളില് രോഗം വര്ധിച്ചുവരുകയാണ്. രോഗത്തിെൻറ തീവ്രത കണക്കിലെടുത്ത് ലോകാരോഗ്യ സംഘടന (WHO) എല്ലാ വര്ഷവും ഏപ്രില് 25ന് ലോക മലേറിയ ദിനമായി ആചരിച്ചുവരുകയാണ്.
എന്താണ് മലമ്പനി?
ഏകകോശ ജീവിയായ പാരസൈറ്റ് അഥവാ പരാദങ്ങള് പരത്തുന്ന രോഗമാണ് മലേറിയ എന്നു വിളിക്കുന്ന മലമ്പനി.
- കടുത്ത പനി,
- വിറയല്,
- തുടര്ച്ചയായ വിയര്പ്പ്,
- വിട്ടുമാറാത്ത തലവേദന,
- ശരീരവേദന,
- ഓക്കാനം, ഛർദ്ദി,
- തൊലിപ്പുറത്തും മൂത്രത്തിലും കാണുന്ന നിറംമാറ്റം തുടങ്ങിയവയാണ് രോഗലക്ഷണങ്ങള്.

രോഗത്തിെൻറ ചരിത്രം
ചരിത്രം പരിശോധിച്ചാല് പുരാതനകാലം മുതല് മനുഷ്യനെ വേട്ടയാടിയിരുന്ന രോഗമാണ് മലേറിയ. നൂറ്റാണ്ടുകള്ക്ക് മുമ്പുതന്നെ ഭൂമിയില് രോഗത്തിെൻറ സാന്നിധ്യം ഉണ്ടായിരുെന്നങ്കിലും പതിനെട്ടാം നൂറ്റാണ്ടില് ഇറ്റലിക്കാരാണ് മലേറിയ എന്ന് പേര് നല്കി രോഗത്തെ തിരിച്ചറിഞ്ഞത്. ചതുപ്പ് നിലങ്ങളില്നിന്നും ഉണ്ടാകുന്ന മലിനമായ വായുവുമായി ബന്ധപ്പെടുത്തിയാണ് ഈ പേര് നല്കിയത്. ‘Bad Air’ എന്ന് അര്ഥം വരുന്ന ‘Mal Air’ എന്ന വാക്കില്നിന്നാണ് മലേറിയ എന്ന പേരുണ്ടായത്. പ്ലാസ്മോഡിയം എന്ന പേരില് അറിയപ്പെടുന്ന ഏകകോശജീവിയാണ് മലമ്പനി പരത്തുന്നത്. 1880ല് ലാവേരന് എന്ന ഫ്രഞ്ച് പട്ടാള ഡോക്ടറാണ് ആഫ്രിക്കയില്വെച്ച് പ്ലാസ്മോഡിയം എന്ന രോഗാണുവിനെ കണ്ടെത്തിയത്. എന്നാല്, അനോഫിലിസ് പെണ്കൊതുകുകളാണ് മലമ്പനി പകര്ത്തുന്നതെന്ന് കണ്ടുപിടിച്ചത് സര് റൊണാള്ഡ് റോസ് ആയിരുന്നു. 1897ല്, ഇന്ത്യയിലെ സെക്കന്ദരബാദില്െവച്ചാണ് അനോഫിലിസ് സ്ടീഫന്സി ഇനം പെണ്കൊതുകുകളുടെ ആമാശയത്തില്നിന്ന് പ്ലാസ്മോഡിയത്തിെൻറ സാന്നിധ്യം അദ്ദേഹം കണ്ടെത്തിയത്.
രോഗം പകരുന്നത്
അനോഫിലിസ് ഇനത്തിൽപെട്ട പെണ്കൊതുകിലൂടെയാണ് പ്ലാസ്മോഡിയം എന്ന ഏകകോശജീവി മനുഷ്യരക്തത്തില് എത്തിച്ചേരുന്നത്. പ്ലാസ്മോഡിയം ശരീരത്തില് പ്രവേശിച്ചാല് 48 മുതല് 72 മണിക്കൂറുകള്ക്കുള്ളില് സാധാരണഗതിയില് രോഗലക്ഷണങ്ങള് പ്രത്യക്ഷപ്പെടുന്നു. രക്തത്തിലൂടെ പരാദങ്ങള് കരളിെൻറ കോശങ്ങളില് പ്രവേശിച്ച് പെരുകുന്നു. തുടര്ന്ന് കരളിെൻറ കോശങ്ങള് നശിക്കുമ്പോള് അത് പരാദങ്ങളെ പുറത്തുവിടുന്നു. അടുത്തഘട്ടത്തില് ഇവ ശരീരത്തിലെ ചുവപ്പു രക്താണുക്കളെ ആക്രമിച്ച് അവിടെയും പെരുകുന്നു. ഇങ്ങനെ പെരുകുന്ന പരാദങ്ങള് ചുവന്ന രക്താണുക്കളെ നശിപ്പിക്കുന്നതോടെ ശരീരത്തില് രോഗലക്ഷണങ്ങള് പ്രത്യക്ഷപ്പെട്ട് തുടങ്ങുന്നു. അപൂര്വം അവസരങ്ങളില് രക്തദാനത്തിലൂടെയും രോഗം പകരാവുന്നതാണ്.
പരാദങ്ങള് അഞ്ചുതരം
മലേറിയ രോഗം പരത്തുന്ന പരാദങ്ങളെ അഞ്ചായി വേര്തിരിച്ചിട്ടുണ്ട്.
- പ്ലാസ്മോഡിയം ഫാല്സിപ്പാരം (Plasmodium falciparum) എന്ന പരാദം തലച്ചോറിനെ ബാധിക്കുന്ന ഏറ്റവും മാരകമായ മലമ്പനി (Cerebral malaria) ഉണ്ടാക്കുന്നു.
- പ്ലാസ്മോഡിയം നോവേല്സി (Plasmodium knowlesi ) എന്ന പരാദം കുരങ്ങുകളിലാണ് രോഗം കൂടുതലായി പരത്തുന്നതെങ്കിലും ഇവ മനുഷ്യരിലും മലമ്പനി ഉണ്ടാക്കാം.
- പ്ലാസ്മോഡിയം വിവാക്സ് (Plasmodium vivax ),
- പ്ലാസ്മോഡിയം ഒവൈല് (Plasmodium ovale ),
- പ്ലാസ്മോഡിയം മലേറിയ (Plasmodium malaria) എന്നിവയും രോഗവാഹകരായ പരാദങ്ങളാണ്.
ചികിത്സ
മലമ്പനി ചികിത്സിക്കാതിരുന്നാല് ഗുരുതരമായ വിളര്ച്ചക്ക് കാരണമാകും. അത് പിന്നീട് ജീവനുതന്നെയും ഭീഷണിയായേക്കാം. അതുകൊണ്ട് രോഗലക്ഷണങ്ങള് വഷളാകുന്നതിനു മുമ്പ്, എത്രയും പെട്ടെന്ന് ചികിത്സ സ്വീകരിക്കണം. പ്രത്യേകിച്ച് ഗര്ഭിണികളിലും കുട്ടികളിലും രോഗലക്ഷണങ്ങള് കണ്ടാല് ഉടന് ആശുപത്രിയെ സമീപിക്കേണ്ടതാണ്. പനി ബാധിച്ചവരുടെ രക്തപരിശോധനയിലൂടെയാണ് രോഗം സ്ഥിരീകരിക്കുന്നത്. രോഗത്തെക്കുറിച്ച് സംശയം തോന്നിയാല് ക്ലോറോക്വിന് (Chloroquine) എന്ന ഗുളികയാണ് പ്രാഥമിക ചികിത്സയുടെ ഭാഗമായി നല്കുന്നത്. രക്ത പരിശോധനയിലൂടെ മലേറിയ ആണെന്ന് ഉറപ്പായാല് രോഗിക്ക് തുടര്ന്ന് സമ്പൂര്ണ ചികിത്സ (Radical treatment) നല്കുന്നു. നിലവില് മലമ്പനിക്കെതിരെ ഫലപ്രദമായ മരുന്നുകള് വിപണിയിലുണ്ട്. പരാദങ്ങളുടെ സ്വഭാവമനുസരിച്ചാണ് മരുന്നുകള് നിര്ണയിക്കുക. ഈ രോഗത്തിനെതിരെ ഫലപ്രദമായ വാക്സിന് നിലവിലില്ല. ചില വാക്സിനുകള് വികസിപ്പിച്ചിട്ടുണ്ടെങ്കിലും പൂര്ണമായ ഫലപ്രാപ്തി തെളിയിക്കാനായിട്ടില്ല. മലേറിയ ബാധിത പ്രദേശങ്ങളില് പോകുന്നവര്ക്ക്, താല്ക്കാലിക പ്രതിരോധത്തിനായി മലമ്പനിക്കെതിരായ മരുന്നുകള് നല്കുകയാണ് പതിവ്.

പ്രതിരോധ പ്രവര്ത്തനങ്ങള്
രോഗബാധയുണ്ടാവുന്ന പ്രദേശങ്ങളിലാണ് പ്രതിരോധ പ്രവര്ത്തനങ്ങള് സാധാരണയായി നടത്തുന്നത്.
- കൊതുക് നശീകരണമാണ് പ്രധാന പ്രവര്ത്തനം.
- കെട്ടിക്കിടക്കുന്ന വെള്ളത്തിലും ഓടകളിലും കീടനാശിനി പ്രയോഗം,
- കുറ്റിക്കാടുകളില് ഫോഗിങ് എന്നുവിളിക്കുന്ന പുകപ്രയോഗം,
- കിണറുകളില് ഗപ്പി എന്ന മത്സ്യത്തെ വളര്ത്തുക എന്നിവയാണ് ജനവാസമുള്ള പരിസരങ്ങളില് നടക്കുന്ന പ്രതിരോധപ്രവര്ത്തനങ്ങള്.
വീടിനകം ശുചിയായി സൂക്ഷിക്കുക, ജനവാതിലുകളിലും വാതിലുകളിലും വീടിനകത്തേക്ക് കൊതുകുകള് പ്രവേശിക്കാതിരിക്കാന് നെറ്റ് പിടിപ്പിക്കുക. കൊതുകുവല ഉപയോഗിക്കുക എന്നിവയാണ് വ്യക്തികള് പാലിക്കേണ്ട പ്രതിരോധ മാര്ഗങ്ങള്.
Don't miss the exclusive news, Stay updated
Subscribe to our Newsletter
By subscribing you agree to our Terms & Conditions.
